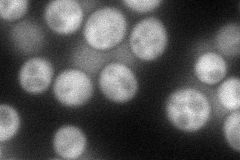
YBR276C
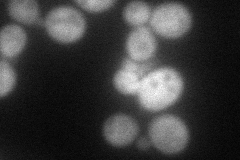
YBR276C
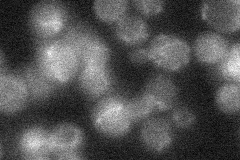
YBR276C
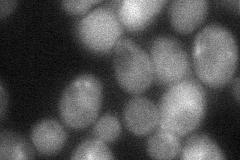
YBR276C
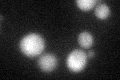
YBR276C

View description
Protein phosphatase with specificity for serine, threonine, and tyrosine residues; has a role in the DNA synthesis phase of the cell cycle
Localization:
Intensity:
Fold change:
Significance:
-
C’ GFP library in SD

cytosol19.43 -
N' NOP1pr-GFP in SD
cytosol72.2595 -
N' TEF2pr-mCherry in SD
cytosol61.118 -
N' NATIVEpr-GFP in SD
below threshold18.3101 -
N' TEF2pr-VC and Cyto-VN in SD
cytosol42.5775 -
C’ GFP library in SD+DTT
cytosol22.51.15No -
C’ GFP library in SD+H2O2

cytosol16.610.85No -
C’ GFP library in Starvation Media

cytosol20.381.04No -
C’ GFP library on the background of Pup2-DaMP

cytosol -
C’ GFP library on the background of CCT mutant

cytosol19.22780.989502No
